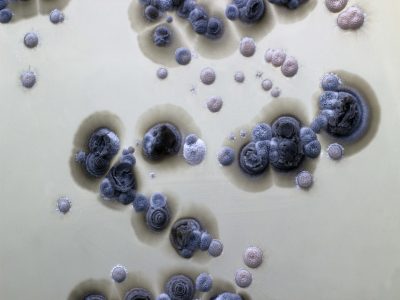
21-Actinomicetos en erupción

Actinomicetos en erupción
Publicada el 22/01/2026
Título: Actinomicetos en erupción
Autor: Fernando Román Hurtado
Fundación MEDINA, Avenida del Conocimiento, 3, 18016, Granada
Descripción: Cepa de Actinophytocola timorensis aislada de un manglar de la localidad de Bentota en Sri Lanka. El género Actinophytocola es un taxón minoritario dentro de la familia Pseudonocardiaceae; la primera cepa de Actinophytocola se aisló en 2010 a partir de una planta en Grecia. Foto tomada mediante una cámara CANON EOS550D y un objetivo EF100mm f/8.8 Macro USM.